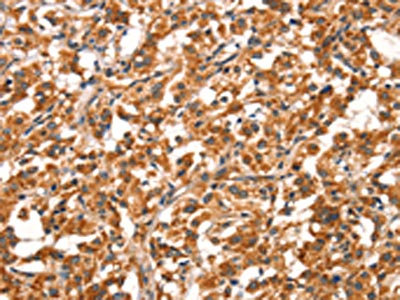

DDAH2 Antibody
-
中文名稱:DDAH2兔多克隆抗體
-
貨號:CSB-PA293420
-
規(guī)格:¥1100
-
圖片:
-
The image on the left is immunohistochemistry of paraffin-embedded Human thyroid cancer tissue using CSB-PA293420(DDAH2 Antibody) at dilution 1/20, on the right is treated with synthetic peptide. (Original magnification: ×200)
-
The image on the left is immunohistochemistry of paraffin-embedded Human brain tissue using CSB-PA293420(DDAH2 Antibody) at dilution 1/20, on the right is treated with synthetic peptide. (Original magnification: ×200)
-
-
其他:
產(chǎn)品詳情
-
Uniprot No.:
-
基因名:DDAH2
-
別名:DDAH antibody; DDAH II antibody; DDAH-2 antibody; DDAH2 antibody; DDAH2_HUMAN antibody; DDAHII antibody; Dimethylargininase 2 antibody; Dimethylargininase-2 antibody; Dimethylarginine dimethylaminohydrolase 2 antibody; Dimethylarginine dimethylaminohydrolase II antibody; G6a antibody; N(G),N(G)-dimethylarginine dimethylaminohydrolase 2 antibody; NG dimethylarginine dimethylamino hydrolase homolog antibody; NG30 antibody; OTTHUMP00000029307 antibody; OTTHUMP00000029310 antibody; OTTHUMP00000174488 antibody; OTTHUMP00000174489 antibody; Protein G6a antibody; S phase protein antibody; S-phase protein antibody
-
宿主:Rabbit
-
反應種屬:Human,Mouse,Rat
-
免疫原:Synthetic peptide of Human DDAH2
-
免疫原種屬:Homo sapiens (Human)
-
標記方式:Non-conjugated
-
抗體亞型:IgG
-
純化方式:Antigen affinity purification
-
濃度:It differs from different batches. Please contact us to confirm it.
-
保存緩沖液:-20°C, pH7.4 PBS, 0.05% NaN3, 40% Glycerol
-
產(chǎn)品提供形式:Liquid
-
應用范圍:ELISA,IHC
-
推薦稀釋比:
Application Recommended Dilution ELISA 1:1000-1:2000 IHC 1:25-1:100 -
Protocols:
-
儲存條件:Upon receipt, store at -20°C or -80°C. Avoid repeated freeze.
-
貨期:Basically, we can dispatch the products out in 1-3 working days after receiving your orders. Delivery time maybe differs from different purchasing way or location, please kindly consult your local distributors for specific delivery time.
-
用途:For Research Use Only. Not for use in diagnostic or therapeutic procedures.
相關產(chǎn)品
靶點詳情
-
功能:Hydrolyzes N(G),N(G)-dimethyl-L-arginine (ADMA) and N(G)-monomethyl-L-arginine (MMA) which act as inhibitors of NOS. Has therefore a role in the regulation of nitric oxide generation.
-
基因功能參考文獻:
- genetic variations in the DDAH2 gene may influence the ADMA concentration and erythropoietin resistance in MHD patients PMID: 28590543
- The main finding from this study was that it demonstrated that the C-allele of rs3087894 in DDAH1 is a risk factor for hypertension in the Kazakh group but a protective factor in the Uygur group. In addition, we did not find any genotype of DDAH1 and DDAH2 associated with hypertension in the Han group. PMID: 26786611
- Exogenous human DDAH2 gene promotes differentiation of rabbit bone marrow-derived endothelial progenitor cells into mature endothelial cells. PMID: 28150318
- expression of DDAH2 is associated with invasiveness of lung adenocarcinoma via tumor angiogenesis PMID: 26515557
- Inhibiting the expression of DDAH1, but not DDAH2, resulted in a significant increase in the sensitivity of the EVT cell line SGHPL-4 to tumour necrosis factor related apoptosis inducing ligand (TRAIL) induced apoptosis PMID: 26082478
- increased ADMA levels in rheumatoid arthritis do not appear to relate to DDAH genetic polymorphisms PMID: 25194333
- The percentage of senescent endothelial progenitor cells increased while the expression of DDAH2 decreased concomitantly with an increase in the plasma levels of asymmetric dimethylarginine in patients with type 2 diabetes mellitus. PMID: 25701782
- DDAH-1 is a specific molecular target for portal pressure reduction, through actions on ADMA-mediated regulation of eNOS activity. PMID: 25152204
- Our results suggest that the rs805304 C allele of the DDAH gene was associated with decreased risk of myocardial infarction and decreased risk of obesity. PMID: 25236572
- Homocysteine disrupts EPCs function via inducing the hypermethylation of DDAH2 promoter, suggesting a key role of epigenetic mechanism in the progression of atherosclerosis PMID: 24934151
- -476 to -469 of the DDAH2 promoter was a NF-kB responsive element and is important for the transactivation of DDAH2. PMID: 24928011
- The rs9267551 functional variant of the DDAH2 gene is associated with chronic kidney disease with carriers of the C allele having a lower risk of renal dysfunction independently from several confounders PMID: 24125425
- Our approaches revealed signature candidates of differentially hypermethylated genes of DDAH2 and DUSP1 which can be further developed as potential biomarkers for OSCC as diagnostic, prognostic and therapeutic targets in the future. PMID: 24155659
- Enhancing pulmonary DDAH II activity attenuates LPS-mediated lung leak in acute lung injury. PMID: 24134589
- There is a significant difference in distribution of DDAH2 gene polymorphism among hemodialysis patients compared to healthy individuals. PMID: 23770786
- DDAH2-1151 A/C polymorphism is associated with Chronic renal impairment in type 2 diabetes. PMID: 23129820
- Glucose-stimulated insulin secretion is increased in Ddah2-transgenic pancreatic islets by 33%, compared to its levels in wild-type mice. PMID: 23430976
- Suppression of DDAH2 expression is a culprit for homocysteine-induced impairments of DDAH/ADMA/NOS/NO pathway in endothelial cells. PMID: 23171931
- Found that SNP rs2272592 in DDAH2 is associated with type 2 diabetes but SNP rs805304 in DDAH2 is not. DDAH2 SNP rs2272592 AG+GG genotypes are associated with genetic susceptibility to type 2 diabetes in Korean population. PMID: 22579530
- No association was observed between the DDAH2 polymorphisms at rs805305 and rs2272592 and coronary heart disease. PMID: 22923027
- A functional polymorphism of the DDAH2 gene may confer increased risk for type 2 diabetes by affecting insulin sensitivity PMID: 22558392
- The -449G single nucleotide polymorphism within the DDAH2 gene was associated with both decreased plasma asymmetric dimethylarginine and an increased likelihood of presenting with "cold" shock in pediatric sepsis. PMID: 22428028
- DDAH-2 could play an important role in IL-1beta-induced NO production and in osteoarthritis pathogenesis. PMID: 21898353
- Low expression of DDAH-2 in placenta and increased serum asymmetric dimethylarginine level might confer susceptibility to preeclampsia. PMID: 19570459
- a possible association between A allele / AA genotype for DDAH2 SNP1 (-1151 C/A, rs805304) and G allele / GG genotype for SNP2 (-449 C/G, rs805305) with CVD in male 35-50 year-old Egyptian patients was observed. PMID: 21677405
- DDAH1 and DDAH2 polymorphisms are strongly and additively associated with serum ADMA concentrations in individuals with type 2 diabetes PMID: 20209122
- Single nucleotide polymorphisms in the DDAH2 gene are associated with blood pressure levels, prevalence of hypertension, and left ventricular mass and function in the general population. PMID: 19666123
- In cultured endothelial cells, heterologously expressed human DDAH II was S-nitrosylated after cytokine induced expression of the inducible NOS isoforms. PMID: 12370443
- DDAH2 expression in endothelial cells is altered by genetic variation in a basal promoter element PMID: 14550280
- messenger RNA and protein were demonstrated in first trimester placental tissue, primary extravillous trophoblasts and extravillous trophoblast-derived cell lines. PMID: 16920729
- Allelic variation for a polymorphism in the DDAH II gene may influence asymmetrical dimethyl arginine concentrations, hence the severity of organ failure in septic shock patients. PMID: 17002794
- The purpose of this study was to investigate whether there is any association between preeclampsia and eNOS, DDAH, and VEGF gene polymorphisms.Polymorphisms in eNOS, DDAH, and VEGF gene do not seem to be risk factors for preeclampsia. PMID: 18251679
- Lysophosphatidylcholine (LPC) impairs DDAH/ADMA/NOS/NO pathway, and DDAH2 gene transfer could improve the LPC-elicited impairments in endothelial cells. PMID: 18342305
- results suggest that the DDAH2 common variant may play a protective role in the development of Intracerebral Hemorrhage, implicating that the DDAH2/ADMA pathway may act as a critical regulator of cerebral small-vessel disorders PMID: 19250061
- DDAH2 mRNA expression is inversely associated with some cardiovascular risk-related features. PMID: 19822957
顯示更多
收起更多
-
亞細胞定位:Cytoplasm. Mitochondrion. Note=Translocates from cytosol to mitochondrion upon IL-1beta stimulation in chondrocytes.
-
蛋白家族:DDAH family
-
組織特異性:Detected in heart, placenta, lung, liver, skeletal muscle, kidney and pancreas, and at very low levels in brain.
-
數(shù)據(jù)庫鏈接:
Most popular with customers
-
-
YWHAB Recombinant Monoclonal Antibody
Applications: ELISA, WB, IHC, IF, FC
Species Reactivity: Human, Mouse, Rat
-
Phospho-YAP1 (S127) Recombinant Monoclonal Antibody
Applications: ELISA, WB, IHC
Species Reactivity: Human
-
-
-
-
-